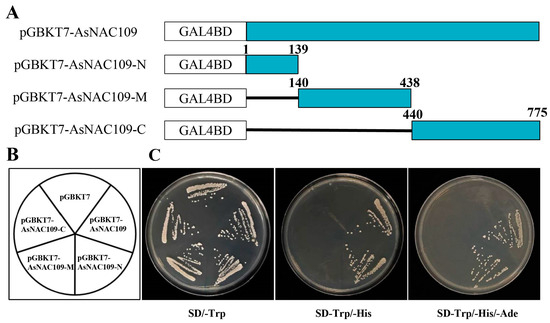

Abstract
The plant-specific NAC gene family is one of the largest transcription factor families, participating in plant growth regulation and stress response. Despite extensive characterization in various plants, our knowledge of the NAC family in oat is lacking. Herein, we identified 333 NAC genes from the latest release of the common oat genome. We provide a comprehensive overview of the oat NAC gene family, covering gene structure, chromosomal localization, phylogenetic characteristics, conserved motif compositions, and gene duplications. AsNAC gene expression in different tissues and the response to various abiotic stresses were characterized using RT-qPCR. The main driver of oat NAC gene family expansion was identified as segmental duplication using collinearity analysis. In addition, the functions of AsNAC109 in regulating abiotic stress tolerance in Arabidopsis were clarified. This is the first genome-wide investigation of the NAC gene family in cultivated oat, which provided a unique resource for subsequent research to elucidate the mechanisms responsible for oat stress tolerance and provides valuable clues for the improvement of stress resistance in cultivated oat.
1. Introduction
Transcription factors (TFs) are proteins which bind to specific promoter regions of target genes and regulate gene expression. Intrinsic cellular processes are regulated by the actions of TFs, including development and differentiation, and signal pathway-mediated responses of cells to external perturbation [1]. Genes of the no apical meristem, Arabidopsis transcription activation factor, and cup-shaped cotyledon (NAC) TF family genes are widely distributed in many types of land plant species. Generally, NACs consist of a nuclear localization signal, a highly conserved N-terminal DNA-binding domain, and a variable-length and sequence C-terminal transcriptional activation domain that interacts with other TFs and probably plays a role in distinct developmental processes [2]. Usually, the N-terminal region has about 160 residues of amino acids and can be further subdivided into five functionally diverse subdomains, termed A-E. Substructural domain A is associated with the formation of functional dimmers that are important to stabilize the protein structure, substructural domains B and E diversify the protein’s functions, and the C and D subdomains are associated with DNA binding [3,4].
In plants, NACs play a critical role in the regulation of many vital biological processes, such as shoot apical meristem formation, secondary wall formation, cell division, embryo and flower organ development, lateral root formation, hormone signaling, leaf senescence, and fruit ripening [5,6]. Moreover, many studies have shown that NACs exert vital functions in regulating plant stress tolerance [7]. In Arabidopsis, ANAC019, ANAC055, and ANAC072 were found to be induced by drought, high salinity, abscisic acid, and their overexpression in transgenic plants resulted in significant improvements in drought tolerance [8]. Overexpression of OsNAC6 and OsSNAC2 in rice enhanced seedling tolerance to drought, salt, and cold stresses [9]. In Arabidopsis, grapevine VvNAC13 overexpression enhanced salt and cold stress tolerance and increased sensitivity to abscisic acid (ABA) [10]. Transformation of the StNAC053 gene from potato into Arabidopsis augmented the transgenic plants’ salt tolerance, increased antioxidant enzyme activities (superoxide dismutase (SOD), catalase (CAT), and peroxidase (POD)), and decreased ROS accumulation in Arabidopsis under high salt stress, thereby enhancing salt tolerance [11]. Silencing the expression of CaNAC2 in chili peppers enhanced the plant’s sensitivity to low temperature, and the plants showed leaf wilting at an early stage under low-temperature stress [12]. Therefore, NAC family genes are important regulators of plant resistance to abiotic stress.
Oat (Avena sativa L.) is among the oldest cultivated crops and is grown widely across the world. In China, oat remains a staple human food in certain arid and saline regions of north China where staple crops such as corn and wheat cannot grow. In recent years, severe changes in the climate, particularly the increased frequency and intensity of droughts, have adversely affected oat yields. Considering the critical role of the NAC genes in stress tolerance, a better understanding of NAC genes in oat will be useful to improve the stress tolerance of oat. Since their first identification in petunia [13], NAC genes have been studied widely in various plants, including rice [14], wheat [15], and Tartary buckwheat [16]. However, the members of the NAC gene family associated with stress tolerance in oat are still largely unknown. The recently published oat reference genome sequence provides an opportunity to systematically characterize the oat NAC gene family. Herein, we present a comprehensive overview of the oat NAC gene family, gene structure, chromosome localization, phylogenetic characteristics, conserved motif compositions, the expression of AsNAC genes in different tissues, and the response to various abiotic stresses were analyzed comprehensively and systematically. In addition, the roles of one AsNAC gene, AsNAC109, in regulating abiotic stress tolerance in Arabidopsis were clarified. The identification of the oat NAC gene family will provide the basis for future function analysis to elucidate the mechanisms responsible for oat stress tolerance and represent valuable data to support molecular-assisted breeding in oat.
2. Results
2.1. Identification, Chromosomal Localization, and Physicochemical Characterization of NAC Family Members in the Oat Genome
Genome-wide analysis of the oat genome identified 333 NAC genes, which were named AsNAC001-AsNAC333 in order of chromosomal position. The predicted properties of the oat NAC genes are shown in Table S1, and the analyses showed that the features of the encoded AsNAC proteins varied widely. The 333 AsNACs ranged from 157 to 747 aa in length, 17,940 to 85,938 Da in molecular weights, and 4.32 to 9.95 in isoelectric points. The 333 NAC genes were distributed on all 21 chromosomes (Figure 1), showing a heterogeneous distribution with a higher distribution on chromosomes Chr2A and Chr2D, with 23 and 28, respectively, and a minimum distribution of only 7 NAC genes on chromosomes Chr4C and Chr3D.

Figure 1.
Oat NAC family genes’ chromosomal distribution. The chromosomes are represented using vertical bars, with the chromosome number appearing at the top. Chromosome length (Mb) is indicated by the scale appearing on the left.
2.2. Phylogenetic and Collinearity Analysis of AsNAC Genes
In order to learn more about the evolutionary history of the NAC gene family and to determine the phylogenetic relationships of the AsNAC genes in oats, we built phylogenetic trees of 117 and 333 NAC genes from Arabidopsis and oats (Figure S2), respectively, using MEGA 11 software. The 333 AsNACs were divided into 14 subgroups, with varying numbers of AsNACs in each group. The largest branch was the NAC3 subfamily, containing 59 AsNACs, and the smallest branch was the NAC3 subfamily, containing only 8 AsNACs.
New genes with similar or different functions can be expanded via gene duplication. Using the MCScan X program, a collinearity study of the NAC genes was carried out to find the duplicates within the AsNAC gene family. The results (Table S3) showed that there were 242 pairs of duplicated genes among the 333 AsNAC genes, with a large number of them located on chromosome Chr 5C (Figure S3). To further understand the phylogeny of the AsNAC gene family and assess if the protein-coding genes are under selective pressure, we calculated the ratio of non-synonymous substitutions (Ka) to synonymous substitutions (Ks). The Ka/Ks analysis (Table S4) revealed that 242 gene pairs had Ka/Ks < < 1, indicating that they were evolutionarily conserved, had experienced strong purifying selection, and that they were functionally conserved during evolution.
2.3. Analysis of Conserved Protein Motifs and Cis-Acting Elements of the AsNAC Genes
To probe the structural evolution of the AsNAC proteins, we analyzed the exon–intron structural patterns of their encoding genes as well as their conserved motifs. Ten conserved protein motifs, Motifs 1–10, with essentially identical distributions were detected in 333 AsNAC proteins. Most AsNACs contain Motif 1, and based on this, we believe that Motif 1 is a conserved motif. The majority of AsNAC proteins within the same subgroup displayed similar motif composition, despite the significant levels of variability between subgroups. For example, the conserved motifs of subclade b are essentially the same, most proteins contain six motifs, from the N-terminus to the C-terminus: Motif 1, Motif 9, Motif 8, Motif 6, Motif 7, Motif 2. Among them, we found that Motif 2 is present in most AsNACs but is specifically absent in subfamily c. Notably, most AsNAC proteins have several specific motifs (1, 5, 4, 3, 6, 2, 7) clustered at the N-terminus.
Their gene structures were analyzed, and there was a high degree of variability in the number of introns and exons, ranging from two to seven exons, although most AsNAC genes have three exons. In general, members of the same subgroup typically share exon/intron configurations and gene lengths. For example, subgroup b and subgroup m contain 1 exon, while subgroups c and d contain 2 or 3 exons (Supplemental Figure S1).
To investigate the functions of the oat NACs, we predicted the promoter region of the AsNAC genes, using the 2000 bp upstream of the transcription start site as the expected promoter region of the AsNAC genes. Multiple phytohormone-responsive elements were identified in addition to light-responsive, stress-responsive, and anaerobic-responsive elements (Figure S4). These comprised 24 light-responsive elements, 7 plant growth and development-related responsive elements, 5 stress-responsive elements, and 10 phytohormone-responsive elements. The CAT-box element is predominantly present in genes that respond to plant growth. Among the stress and phytohormone response-related cis elements, antioxidant response elements (AREs) are essential for anaerobic induction of cis elements, MYB3-binding promoter motifs (MBSs) are associated with drought responses, and long terminal repeats (LTRs) are involved in stress responses, such as high and low temperatures, methylation inhibitors, irradiation, and high salt. ABA-responsive elements (ABREs) are associated with the response to ABA, CGTCA and TGACG motifs are associated with the response to methyl jasmonate (MeJA), and P-boxes are associated with the response to gibberellic acid (GA). These elements of the response class may enable the AsNAC genes to play an important role in abiotic stresses.
2.4. Expression Pattern Analysis of the AsNAC Genes
Oat NAC gene expression was analyzed in four tissue types and under seven stress treatments (Figure S5). Analysis of the results showed that there were significant variations in the expression of genes in the leaves, stems, spikes, and roots, with the highest expression found in the latter. The expression levels of the vast majority of AsNAC genes were upregulated under low-temperature, high-temperature, drought, drought high-temperature, salt, alkali, and saline stresses, with the most significant upregulation being observed under drought and high-temperature stress.
2.5. Functional Characterization of the Transcriptional Activation Activity of the AsNAC109 Gene
To determine the transactivation ability of AsNAC109, we performed a yeast one-hybrid assay. Full-length AsNAC109 and different fragments were cloned into pGBKT7 vector to identify its ability to activate transcription of the marker HIS3 gene. Defective media screening assay showed that yeast containing pGBKT7, pGBKT7-AsNAC109, pGBKT7-AsNAC109-N, pGBKT7-AsNAC109-M, and pGBKT7-AsNAC109-C plasmids could grow on SD/-Trp single-deficient medium (Figure 2). By contrast, yeast with pGBKT7, pGBKT7-AsNAC109-M, and pGBKT7-AsNAC109-C plasmids failed to grow on double-deficient and triple-deficient media, whereas yeast with full-length of AsNAC109 and N-terminus were able to grow normally. These results demonstrated that the AsNAC109 transcription factor possesses the ability to activate transcription, and that this activity is mostly concentrated at the N-terminus of the factor rather than the C-terminus.
Figure 2.
Transactivation AsNAC109 assayed in yeast. (A) Structures of the effectors employed in this experiment. In vector pGBKT7, the DNA-binding domain of GAL4 was fused to the full-length ORF, the N-terminal region, or the C-terminal region of AsNAC109. (B) Growth on selective media of AH109 cells harboring each of the constructs, the empty vector (negative control) or the positive control. (C) Transactivation was tested according to growth on SD-Trp, SD-Trp-His, and SD-Trp-His-Ade.
2.6. Subcellular Localization of AsNAC109
To clarify the location of AsNAC109 in cells, pCAMBIA1300-GFP empty vector and pCAMBIA1300-AsNAC109-GFP recombinant vector were transiently expressed in N. benthamiana young leaves. Confocal imaging showed that the control cells emitted green, fluorescent signals at both the cell membrane and the nucleus (Figure 3), demonstrating that the pCAMBIA1300-GFP fusion protein was expressed at the cell membrane and nucleus. The fusion protein AsNAC109-GFP mainly emitted green, fluorescent signals in the nucleus, suggesting that AsNAC109 is mainly located in the nucleus, which is consistent with the characteristics of transcription factors.

Figure 3.
Subcellular localization of AsNAC109.bar = 20 μm; GFP: bright field, BF: green fluorescence, Merged: superimposed field, photographs were taken in three fields of view.
2.7. Identification of the Phenotype of AsNAC109-Overexpressing Arabidopsis and Determination of Physiological Indices
To identify the function of the AsNAC109 gene, the overexpression vector pCAMBIA1300 vector with a 35S promoter was constructed and transformed into Arabidopsis. After antibiotic screening and PCR validation, four homozygous transgenic lines over-expressing AsNAC109 (OE) were selected for further analysis, and their AsNAC109 expression levels showed differences using RT-qPCR, while the control line (WT) had no detectable AsNAC109 transcript. Phenotypic characterization tests showed that transgenic and WT plants behaved significantly differently under stress conditions. In general, the WT plants were significantly smaller and the root system was shorter, and the leaves mostly appeared to be yellowish or white under salt, alkali, and saline stresses, compared with those in plants overexpressing AsNAC109 (Figure 4). The primary root lengths of the four AsNAC109-overexpressing Arabidopsis lines were longer than those of the WT plants under different stress conditions, and they were significantly different from each other. In addition, the results of the preliminary resistance characterization of the AsNAC109-overexpressing Arabidopsis lines showed that they had stronger resistance to stress than the WT.

Figure 4.
The root lengths of AsNAC109-overexpressing Arabidopsis lines under drought, salt, alkali, and saline stresses. (A) (a) Phenotypes of plants grown in MS medium; (b) phenotypes of plants grown in mannitol medium for 7 d; (c) phenotypes of plants grown in NaCl medium for 7 d; (d) phenotypes of plants grown in Na2CO3 and NaHCO3 (1:1) medium for 7 d; (e) phenotypes of plants grown in NaCl, Na2SO4, and NaHCO3 (1:1:1) medium for 7 d (WT represents wild-type Arabidopsis, OE1, OE2, OE3, and OE4 represent four AsNAC109-overexpressing Arabidopsis lines). (B) Identification of AsNAC109 transgenic lines by RT-qPCR. The relative expression levels of the over-expression (OE) lines were determined by dividing their expression levels by that of line 1 which had the lowest expression level. (C) Mean primary root length of Arabidopsis plants under different stress treatments. (* marks significance at a level of 0.05, ** marks significance at a level of 0.01, and *** marks significance at a level of 0.001).
To further validate the resistance of AsNAC109-overexpressing Arabidopsis in soil and the resistance regulatory mechanism of the AsNAC109 gene, resistance in soil and physiological indices under stress treatments were assessed (Figure 5). After 14 d of stress treatment, some of the leaves of WT Arabidopsis thaliana turned yellow, and the plants were dwarfed. After stress treatment of AsNAC109-overexpressing Arabidopsis, the leaf tips of the old leaves turned yellow, but the inner young leaves remained green, and overall, the leaves did not show symptoms of dryness, the degree of stress injury was less than that of the WT, and their growth was significantly better than that of the WT. The AsNAC109-overexpressing Arabidopsis lines exhibited reduced MDA levels and increased POD and SOD enzyme activity in comparison with the WT. The higher SOD activities of the AsNAC109-overexpressing Arabidopsis lines indicated that the transgenic Arabidopsis had an enhanced ability to scavenge ROS. The accumulation of MDA leads to membrane lipid peroxidation, which impairs the membrane structure, thus impacting a series of physiological and biochemical processes. The significantly decreased accumulation of MDA in the transgenic Arabidopsis suggested that it suffered a lower degree of cellular damage under adverse stress.

Figure 5.
Phenotypic changes and the identification of physiological indicators of AsNAC109 overexpression in Arabidopsis thaliana under stress conditions. (A) The growth of Arabidopsis under normal conditions, drought stress, salt stress, alkali stress, and saline and alkaline stress, respectively. (B) Activity of superoxide dismutase (SOD). (C) Activity of peroxidase (POD). (D) Malondialdehyde (MDA) content. OE1, OE2, OE3, and OE4 represent different AsNAC109-overexpressing Arabidopsis lines. * indicates a significant correlation at the 0.05 level, ** significant correlation at the 0.01 level, *** significant correlation at the 0.001 level, **** significant correlation at the 0.0001 level.
The ionic concentrations of Na+, Ca2+, K+, and Cl− ions were examined in salt- and alkali-stressed transgenic Arabidopsis and WT plants (Figure 6). The results showed that the concentrations of Na+ and Cl− in the transgenic Arabidopsis were lower than those in the WT under salt and alkali stress, while the concentrations of Ca2+ and K+ were higher in the transgenic Arabidopsis than in the WT. This suggested that the AsNAC109-overexpressing Arabidopsis possessed stronger ROS scavenging ability, which reduced their Na+ toxicity and oxidative damage under salt and alkali stresses, leading to enhanced salt and alkali tolerance.

Figure 6.
Ion concentrations under salt and alkali stress. (A) Ion concentrations of wild-type and AsNAC109-overexpressing Arabidopsis plants under salt stress. (B) Ion concentrations of wild-type and AsNAC109-overexpressing Arabidopsis plants under alkali stress.
3. Discussion
The important regulatory role of NAC TFs in plant growth and their potential value for utilization in plant improvement have led to NAC genes being identified at a genome-wide level in various plant species [17]. However, the oat genome is large and complex; therefore, we know little about the oat NAC gene family. Herein, based on the recently published cultivated oat genome, we performed a genome-wide identification of NAC domain TF genes in cultivated oat. Systematic analysis of gene structure, duplication events, phylogenetic relationships, and expression patterns in various tissues and in response to abiotic stresses were conducted. Moreover, the roles of one AsNAC gene, AsNAC109, in regulating abiotic stress tolerance in yeast and Arabidopsis were identified. The results of this study will further our understanding of NAC genes and help to elucidate the evolution and possible functions of NAC domain proteins in cultivated oat.
A previous study showed that the number of NAC genes diverged markedly among 160 tested species, with Brassica napus having the highest number (410) and Marchantia polymorpha having the lowest (9) [17]. In this study, a genome-wide search identified 333 NAC genes in cultivated oat, which is higher than that in Arabidopsis (115), rice (151) [18], and soybean (152) [19] but lower than that in bread wheat (488) [15], oil-seed rape (410) [17], and alfalfa (421) [20]. Compared with that in other plant species, the number of NAC genes identified in cultivated oat is relatively high. In most cases, differences in the number of NAC genes could be attributed to differences in the genome size of each species [21]. Therefore, the high number of NAC genes in oat is partly caused by the derivation of the cultivated hexaploid oat from the hybridization of three diploid ancestors, thus containing six sets of chromosomes (AA, CC, and DD subgenomes). Gene expansion is mostly caused by gene duplication events, including tandem, segmental, and whole-genome duplication [22]. Collinearity analysis showed that there are 157 duplication events among oat NAC genes, comprising 146 segmental duplication events and 11 tandem duplication events, indicating that segmental duplication dominated oat gene expansion events. Similar results were reported for Miscanthus sinensis [21] and Triticum dicoccoides [23]. Gene duplication can be driven by DNA break repair. In bread wheat, massive numbers of small-scale interchromosomal gene duplications took place in the genome following the repair of double-strand DNA breaks [15]. Analysis of the oat genome sequence showed a mosaic-like genome architecture resulting from frequent genomic rearrangements, which might also have contributed to NAC gene family expansion. Gene duplication is a fundamental process in evolution, promoting genetic redundancy and robustness, giving rise to new genes and functionalities by providing new nucleotide sequences and contributing to the adaptation to climate change over time [24]. Therefore, the study of gene duplication events can help to understand gene function and the molecular processes behind the development of some particular features.
Considering the hexaploidy of cultivated oat, we expected that three homologous copies of each gene would be present in each of the three subgenomes, resulting in homologous groups. In this study, analysis of NAC genes on each chromosome showed that the NAC genes of cultivated oat are distributed unevenly among the chromosomes, similar to the identified NAC genes in other plants, such as rice [14], wheat [15], and soybean [19]. The numbers of oat NAC genes identified per chromosome varies from 7 to 28. For most NACs, the number of each NAC gene identified per homolog varies frequently, indicating unequal preservation of homologous NAC genes. The number of NAC genes identified on each oat subgenome group also varied, with the highest number on subgenome A (118) and the lowest on subgenome C (105), which is different from wheat, in which Borrill et al. [15] found that most of the NAC genes retained their corresponding copies in all three subgenomes of wheat. Analysis of the oat genome sequence showed that, unlike wheat, the oat subgenome exhibits an unbalanced number of genes, specifically, the C subgenome appears to have 12% fewer genes than the A or D subgenomes [25], which is consistent with our findings.
Typically, prokaryotic genes are intronless; however, eukaryotes also contain a proportion of intronless genes. Of the 333 identified AsNAC genes, about 13% (44) are intronless, which is lower than the proportion of intronless NAC genes in wheat (19%). A lack of introns is a feature of retrotransposons, which “copy and paste” the DNA of the retrotransposon to a new location in the genome, leading to the expansion of certain genes or genetic elements in a genome [26]. Compared with oat, wheat has more intronless NAC genes, suggesting more retrotransposition events in the wheat genome. Moreover, we found that the distribution of AsNAC intronless genes on each chromosome did not correlate with the distribution of the whole AsNAC gene family. For example, although chromosome 7D has 19 NAC genes, which is higher than average, no intronless NAC genes were observed on chromosome 7D. Whereas chromosome 3D, which contains only seven NAC genes, has one intronless NAC gene. Chromosome 1A, which has a similar number of NAC genes (20) to Chromosome 7D, has the highest number intronless NAC genes (10). This divergence of NAC genes suggests that several mutations or loss of sequences might have occurred in specific homologs of the NAC gene family. Furthermore, most of the intronless AsNAC genes are classified into homologous groups, which suggested that retrotransposition events likely occurred before the polyploidization of oat.
The NAC TF gene family is one of the largest families identified to date [23]. Although the NAC gene structure is relatively conserved, the lengths, predicted molecular masses of the encoded proteins, and their pI, vary among NAC genes. Based on the phylogenetic analysis of NAC gene sequences from oat and the model plant Arabidopsis, we further divided the AsNAC gene family into 14 distinct clades comprising NAC genes with highly similar structures. Analysis of gene expression patterns can provide clues to protein function. Consequently, we used RT-qPCR to determine the NAC gene expression profiles in various tissues and environments. The results of RT-qPCR showed that, in general, for different tissues, NAC genes were highly expressed in roots and under drought and high-temperature conditions. The TERN subgroup, which contains h and k motifs, demonstrated higher root expression than the other subgroups. Interestingly, most members of the TERN subfamily, such as AsNAC117/187/186/071/316/287/177/081, also showed high levels of expression under different stress treatments. Roots are an important organ of plants to perceive harmful changes in the external environment [27]. Thus, AsNAC genes showing marked root-specific expression might exert vital functions in the response to abiotic stress. NAC TFs in the TERN subgroup contain a conserved WKATGSPG sequence, similar to that in WRKY proteins, suggesting a DNA-binding function for this conserved domain and the existence of a common evolutionary ancestor of the NAC-TF and WRKY TF families [28]. In cotton, TERN subgroup member GbNAC1 is highly expressed in roots and stems. Analysis of the overexpression of GbNAC1 in Arabidopsis treated with different stresses suggested that GbNAC1 has an important function in abiotic stress resistance [29].
In a phylogenetic tree, genes on the same branch are likely to have similar functions and expression profiles [23,30]. In this study, we found that genes in the same clade with detected expression exhibited dissimilar expression profiles. For example, unlike other TERN subgroup members, the expression of AsNAC023 was not induced by the stress conditions adopted in this study, although it was highly expressed in roots, which suggested that it might only function in root development. All members of TIP subgroup exhibited higher expression under salt stress; however, only NAC058 also showed high expression under drought stress, the expression of other members did not change significantly, and the expression levels of AsNAC307/091/196/267 were downregulated. Similar results were reported in mung bean and wheat [15,31]. Interestingly, tandem duplicated genes also exhibited dissimilar expression profiles. AsNAC187, a tandem duplicated gene of AsNAC188, showed high expression in the roots and the ears of grain, while AsNAC188 did not. Moreover, cold, salt, and alkali stress induced AsNAC187 expression, while AsNAC188 expression was inhibited by the three stresses. This difference between tandem duplicated genes indicates that they might have undergone divergent evolution and acquired new functions, leading to the development of distinct adaptations suited to various environmental conditions. This suggests that although NAC genes evolved from a common ancestor, they underwent multiple replication events during differentiation and species formation, which resulted in divergent functions during plant growth and development. Moreover, analysis of the selection pressures on the NAC genes of cultivated oats showed that most tandem duplicated genes showed significant overall purifying selection (Ka/Ks < < 1), suggesting that purifying selection acted as the primary force, and some of the retained duplicated genes are still functional and might have an adaptive advantage.
Plant responses to abiotic stress, e.g., salinity, cold, drought, and heat, involve NAC TFs. However, we lack knowledge regarding the involvement of NAC TFs in the oat abiotic stress response. Previously, we obtained a new AsNAC gene, designated AsNAC109, which shows differential expression under stress; however, its function was largely unknown. To further clarify the roles of AsNAC109 under abiotic stress, we genetically transformed AsNAC109 into Arabidopsis. Investigation of phenotypic and stress-related physiological characteristics showed that stress tolerance was significantly enhanced in the transgenic plants compared with those in the WT. The length of the roots was longer, and the Ca2+/K+ contents were higher in the transgenic plants than in the WT plants under stress, suggesting that the AsNAC109-overexpressing plants suffered lower ion toxicity under salt and alkali stresses relative to the WT plants, and were better able to maintain ion homeostasis in vivo. Compared with WT, ROS accumulation in the transgenic plants was lower, and antioxidant enzyme activity was higher, indicating that AsNAC109 might enhance stress tolerance by promoting ROS scavenging. The transcription of a wide variety of genes might be regulated by NAC TFs, resulting in enhanced tolerance to various stresses. Similar results have been obtained in other studies of NAC genes. In rice, knockout of OsNAC45, which belongs to the NAM subgroup like AsNAC109, resulted in more ROS accumulation and increased sensitivity of rice to salt stress [32]. In Tamarix hispida, ThNAC4 overexpression in transgenic T. hispida and Arabidopsis enhanced antioxidant enzyme activities (SOD, POD, and GST) and the contents of osmoprotectants (proline and trehalose) under stress conditions [33]. Wheat TaNAC2 overexpression in Arabidopsis resulted in enhanced resistance to drought, salt, and cold stresses, as demonstrated by elevated expression of the abiotic stress-responsive gene and other physiological indices [34]. Taken together, these findings imply that AsNAC109 is a positive regulator of stress tolerance and may have a significant impact on it.
4. Materials and Methods
4.1. Growth Conditions and Plant Materials
Seeds of the common oat cultivar ‘HanYou-5’ were provided by The Institute of Crop Sciences, Chinese Academy of Agricultural Sciences, Beijing, China. The seeds were sterilized and incubated in germination boxes in a 16 h/8 h (light/dark) greenhouse at 28/25 °C and 70% relative humidity. Samples were obtained from four different parts of the leaves, stems, and roots of oat seedlings and the spikes of oats at the tasseling stage and placed at −80 °C. Oat seedlings grown for 7 d were subjected to drought (20% PEG6000), salt (150 mmol/L NaCl), alkali (100 mmol/L Na2CO3 + NaHCO3), saline (100 mmol/L NaCl, Na2SO4 + NaHCO3), cold (4 °C), and heat (42 °C) stress treatments. The roots, stems, and leaves of oat seedlings and spikes at the heading stage were harvested and placed at −80 °C until the extraction of total RNA. Oat seeds were sterilized and placed in a germination box and grown hydroponically, protected from light, for 10 days, and their leaves were then collected to prepare protoplasts [35].
Wild-type (WT) and T2 generation transgenic Arabidopsis seeds were sterilized and sown on normal 1/2 Murashige and Skoog (MS) medium for 4 d before stress treatment. Seedlings with uniform growth were selected and transplanted into different stress media, including drought (125 mmol/L PEG6000), salt (100 mmol/L NaCl), alkali (50 mmol/L Na2CO3+NaHCO3), and saline (100 mmol/L NaCl, Na2SO4 + NaHCO3), and six plants of each of WT and transgenic Arabidopsis, with three biological replicates, were treated. Photographs were taken, and root lengths were measured after vertical incubation for 7 d. For physiological measurement, transgenic Arabidopsis and WT control plants were grown in 1/2 MS medium for about 7 d, and individuals with a consistent growth state were selected and transplanted into pots with a matrix of Metromix 350 (Sungro Horticultural, Agawam, MA, USA). Three weeks after transplantation, the plants were subjected to the different stress treatments mentioned above, and the leaves were collected to determine the physiological indexes.
4.2. Genome-Wide Identification of Oat AsNAC Genes and Prediction of Physicochemical Properties of the Encoded Proteins
The oat and Arabidopsis genome sequence and annotation information were down-loaded from the NCBI database (https://www.ncbi.nlm.nih.gov/datasets/genome/GCA_916181665.1/ accessed on 2 February 2022 and https://www.ncbi.nlm.nih.gov/datasets/genome/GCF_000001735.4/ accessed on 15 March 2022). The NAC-conserved structural domain sequence (PF01849) was obtained from the PFAM database (http://pfam.xfam.org/ accessed on 13 April 2022). NAC family members were identified using HMMER 3.0, and the results were filtered based on a score value of greater than 90 and an E-value of less than 1 × 10−5 [36]. The NAC homologous sequences in oats were then identified based on Arabidopsis NAC protein sequences. The intersections of the PFAM and BLAST screening results were identified and validated using the Conserved Domain Database (CDD) database (https://www.ncbi.nlm.nih.gov/cdd/ accessed on 20 June 2022) to finally screen the oat NAC family genes. Using EXPASY, physicochemical characteristics for the AsNAC family members were predicted, including molecular weight and isoelectric point. (https://web.expasy.org/protparam/ accessed on 24 August 2022) [37].
4.3. Chromosomal Localization, Collinearity Analysis, and Phylogeny Analysis of the NAC Gene Family in Oat
Based on the oat genomic data, the length and chromosomal position of each found AsNAC gene were calculated and displayed using MapChart 2.32 [38]. The Multiple Collinearity Scan toolbox (MCScanX http://chibba.pgml.uga.edu/mcscan2/#tm accessed on 2 December 2022) was employed to analyze the tandem repeats in AsNAC genes [39], and the AsNAC gene duplicates were identified by Tbtools 2.0 [40].
The NAC protein sequences of the identified pairs from Arabidopsis and oat were compared using the Clustalx tool (http://www.clustal.org/clustal2/ accessed on 15 December 2022) [41]. The NJ method in MEGA-X was then used to create an unrooted phylogenetic tree with bootstrap support from 1000 replications [42]. The evolutionary tree was plotted using iTOL (https://itol.embl.de/ accessed on 25 December 2022).
4.4. Gene Structure and Analysis of Conserved Motifs and Cis-Acting Elements of the AsNAC Gene Family
Gene Structure Display Server 2.0, an online application, was used to evaluate the AsNAC gene structures (GSDS, http://gsds.cbi.pku.edu.cn/ accessed on 12 March 2023). AsNAC protein-conserved motifs were searched using MEME for Motif Elicitation (MEME) (http://meme-suite.org/tools/meme accessed on 28 March 2023; number of conserved motifs = 10, otherwise the system default parameters were used). In order to identify cis-acting elements, the promoter regions of the AsNAC genes were taken from the oat genome sequence and submitted to PlantCARE (https://bioinformatics.psb.ugent.be/ accessed on 18 May 2023) [43]. The results were collated and visualized using TBtools 2.0.
4.5. Expression Pattern Analysis of Oat NAC Gene Family Members Using Quantitative Real-Time Reverse-Transcription PCR (RT-qPCR)
RT-qPCR was carried out as described previously, and the internal housekeeping control gene was EF1A (encoding Elongation factor 1α) [44]. The RT-qPCR primers were designed using Primer Express and are listed in Supplementary Data Table S2. An examination of the sodium dodecyl sulfate (SDS) dissociation curve was used to confirm the amplification’s specificity. Melting curve analysis was employed to verify that each pair of primers produced a distinct amplicon. Gene expression levels were analyzed using the 2−ΔΔCt method [45]. Expression data were visualized as heatmaps using TBtools 2.0 software.
4.6. AsNAC109 Transcriptional Self-Activating Activity and Subcellular Localization
AsNAC109 was identified in oat in response to salt stress [46]. To identify the transcriptional activity of the AsNAC109 gene, the full-length gene, DNA encoding the N-terminus (1–139 aa), DNA encoding the middle region (140–438 aa), and DNA encoding the C-terminus (440–775 aa) were ligated into vector pGBKT7 separately, while empty pGBKT7 comprised the negative control. The recombinant plasmids and the empty vector were transformed into AH109 yeast cells, and the positive transformants were first screened on single-deficient medium (SD/-Trp), followed by lineage culture on SD/-Trp, SD/-Trp/-His, and SD/-Trp/-His/-Ade medium [47]. For subcellular localization, AsNAC109 was ligated into pCAMBIA1300 vector with a 35S promoter and GFP tag, and control (35S:GFP) was then transformed into Agrobacterium tumefaciens strain GV1301 using the freeze–thaw method. Transient expression of 35S: AsNAC109-GFP in tobacco (Nicotiana benthamiana) leaves was performed by agroinfiltration [48]. After agroinfiltration, the fluorescent signal was recorded with a confocal laser scanning microscope (LSM980, Carl Zeiss Microscopy GmbH., Jena, Thüringen, Germany).
4.7. Functional Analysis of AsNAC109
The AsNAC109 ORF was amplified using primers listed in Table S2 and ligated into pCAMBIA1300 vector with a 35S promoter. The constructed overexpression vector was transformed into Agrobacterium GV1301 as above and then transformed into Arabidopsis Col-0 by the Agrobacterium tumefaciens-mediated floral dip method. The transformants were selected on 50 mgL−1 of kanamycin and further verified by PCR. Homozygous T3 progeny was used for the phenotypic analysis and RT-qPCR, as is shown above.
The length of the primary roots was measured for AsNAC109-overexpressing transformants (OE1, OE2, OE3, and OE4) and the WT after 7 d of vertical incubation on stress medium and MS medium. For physiological index measurement, normally grown and stress-treated Arabidopsis leaves were collected, and their malondialdehyde (MDA) content was measured using the thiobarbituric acid (TAB) method [49]. Peroxidase (POD) was measured by the method of [50]. A previously published method was used to determine the superoxide dismutase (SOD) activity [51]. Na+, Ca2+, and K+ contents were measured using flame photometry [52], and the Cl− content was measured using a colorimetric method [53].
5. Conclusions
Herein, the oat NAC gene family was subjected to genome-wide analysis based on the recently published cultivated oat genome. The identified 333 AsNAC genes were classified into 14 subgroups. Their chromosomal distribution, structure, gene duplications, conserved motifs, phylogenetic relationships, and expression patterns in various tissues and under abiotic stresses were further investigated. Collinearity analysis identified that the main driver of NAC gene expansion was segmental duplication. Duplicated genes might undergo divergent evolution and exhibit dissimilar expression profiles, leading to the development of distinct adaptations suited to various environmental conditions. Additionally, we identified a new stress-responsive NAC gene, AsNAC109. Overexpression of AsNAC109 increased antioxidant enzyme activities, and reduced ionic toxicity and oxidative damage, which significantly improved the stress resistance of transgenic plants. These findings provide new insights into the regulatory functions of NAC genes in the underlying mechanisms of stress tolerance in cultivated oat. Our findings also provide valuable candidate gene resources for genetic engineering and molecular breeding to improve oat abiotic stress tolerance.
Supplementary Materials
The following supporting information can be downloaded at: https://www.mdpi.com/article/10.3390/plants13071017/s1, Figure S1: Motif analysis of oat NAC gene structure and its encoded protein; Figure S2: Phylogenetic assessment of oat and Arabidopsis NAC proteins. The neighbor-joining (NJ) method (including 1000 bootstrap replications) was used to construct the phylogenetic tree. According to the phylogenetic tree, the AsNAC proteins were classified into 14 subgroups (indicated using different colors in the tree); Figure S3: AsNAC gene duplication events. Chromosomes are indicated using different colored squares, and duplicated pairs of NAC genes are indicated using red lines; Figure S4: Analysis of cis-acting elements of the AsNAC gene promoter. A heatmap of the number of cis elements is shown on the left. The color of the bar represents the classification, and the size of the circle represents the number of cis acting elements. Different colored boxes indicate: blue, light-responsive cis elements; yellow, the plant growth-related cis elements; purple, stress-responsive cis element; orange, phytohormone-reactive cis elements. The histogram on the right shows a summary of each type of cis element according to the abovementioned color scheme; Figure S5: AsNAC gene expression patterns under various abiotic stresses and in various tissues, as determined using RT-qPCR. AsNAC gene expression patterns in different tissues and under different abiotic stresses. Root (R), stem (ST), leaf (LF), spike (SP), low temperature (LT), high temperature (HT), drought (DR), drought and high temperature (DH), salt (SA), base (BA), salt and base (SB), Control (CK); Table S1: Physicochemical properties of AsNAC gene; Table S2: The Primers List Used RT-qPCR and Subcellular Localization; Table S3: Homologous gene pairs between oat AsNAC genes; Table S4: Ka/Ks Ratios of AsNAC Genes; Table S5: Conservative Motif Information of oat; Table S6: Characteristics of cis-acting regulatory elements in the promoter region of NAC genes in Oat.
Author Contributions
Conceptualization, B.W. and J.J.; methodology, Y.X.; software, J.C.; validation, Y.X., J.C. and H.H.; formal analysis, L.Y.; data curation, H.H.; writing—original draft preparation, Y.X.; writing—review and editing, B.W.; visualization, J.J.; supervision, J.J.; project administration, B.W.; funding acquisition, B.W. All authors have read and agreed to the published version of the manuscript.
Funding
This research was funded by the Modern Seed Industry Technology Innovation Program of Hebei Province, grant number 21326305D; the National Key Research and Development Program of China, grant number 2023YFD1202703; and the China Scholarship Council, grant number [2020]1417.
Data Availability Statement
The data presented in this study are available on request from the corresponding author.
Conflicts of Interest
The authors declare no conflicts of interest.
References
- Weidemüller, P.; Kholmatov, M.; Petsalaki, E.; Zaugg, J.B. Transcription factors: Bridge between cell signaling and gene regulation. Proteomics 2000, 21, 23–24. [Google Scholar] [CrossRef]
- Puranik, S.; Sahu, P.P.; Srivastava, P.S.; Prasad, M. NAC proteins: Regulation and role in stress tolerance. Trends Plant Sci. 2012, 17, 369–381. [Google Scholar] [CrossRef]
- Ernst, H.A.; Nina, A.O.; Skriver, K.; Larsen, S.; Leggio, L.L. Structure of the conserved domain of ANAC, a member of the NAC family of transcription factors. EMBO Rep. 2004, 5, 297–303. [Google Scholar] [CrossRef] [PubMed]
- Shen, S.; Zhang, Q.; Shi, Y.; Sun, Z.; Zhang, Q.; Hou, S.; Wu, R.; Jiang, L.; Zhao, X.; Guo, Y. Genome-Wide Analysis of the NAC Domain Transcription Factor Gene Family in Theobroma cacao. Genes 2020, 11, 35. [Google Scholar] [CrossRef] [PubMed]
- Olsen, A.N.; Ernst, H.A.; Leggio, L.L.; Skriver, K. NAC transcription factors: Structurally distinct, functionally diverse. Trends Plant Sci. 2005, 10, 79–87. [Google Scholar] [CrossRef]
- Sun, L.; Liu, L.P.; Wang, Y.Z.; Yang, L.; Wang, M.J.; Liu, J.X. NAC103, a NAC family transcription factor, regulates ABA response during seed germination and seedling growth in Arabidopsis. Planta 2000, 252, 95. [Google Scholar] [CrossRef] [PubMed]
- Nuruzzaman, M.; Sharoni, A.M.; Kikuchi, S. Roles of NAC transcription factors in the regulation of biotic and abiotic stress responses in plants. Front. Microbiol. 2013, 4, 248. [Google Scholar] [CrossRef] [PubMed]
- Tran, L.S.; Nakashima, K.; Sakuma, Y.; Simpson, S.D.; Fujita, Y.; Maruyama, K.; Fujita, M.; Seki, M.; Shinozaki, K.; Yamaguchi-Shinozaki, K. Isolation and functional analysis of Arabidopsis stress-inducible NAC transcription factors that bind to a drought-responsive cis-element in the early responsive to dehydration stress 1 promoter. Plant Cell 2004, 16, 2481–2498. [Google Scholar] [CrossRef]
- Li, M.; Chen, R.; Jiang, Q.; Sun, X.; Zhang, H.; Hu, Z. GmNAC06, a NAC domain transcription factor enhances salt stress tolerance in soybean. Plant Mol. Biol. 2021, 105, 333–345. [Google Scholar] [CrossRef] [PubMed]
- Ju, Y.L.; Yue, X.F.; Min, Z.; Wang, X.H.; Fang, Y.L.; Zhang, J.X. VvNAC17, a novel stress-responsive grapevine (Vitis vinifera L.) NAC transcription factor, increases sensitivity to abscisic acid and enhances salinity, freezing, and drought tolerance in transgenic Arabidopsis. Plant Physiol. Biochem. 2019, 146, 98–111. [Google Scholar] [CrossRef]
- Wang, Q.; Guo, C.; Li, Z.; Sun, J.; Deng, Z.; Wen, L.; Li, X.; Guo, Y. Potato NAC Transcription Factor StNAC053 Enhances Salt and Drought Tolerance in Transgenic Arabidopsis. Int. J. Mol. Sci. 2021, 22, 2568. [Google Scholar] [CrossRef]
- Guo, W.; Wang, S.; Chen, R.; Chen, B.; Du, X.; Yin, Y.; Gong, Z.; Zhang, Y. Characterization and expression profile of CaNAC2 pepper gene. Front. Plant Sci. 2015, 6, 755. [Google Scholar] [CrossRef]
- Souer, E.; Van, H.A.; Kloos, D.; Mol, J.; Koes, R. The no apical meristem gene of petunia is required for pattern formation in embryos and flowers and is expressed at meristem and primordia boundaries. Cell 1996, 85, 159–170. [Google Scholar] [CrossRef]
- Kikuchi, K.; Ueguchi-Tanaka, M.; Yoshida, K.T.; Nagato, Y.; Matsusoka, M.; Hirano, H.Y. Molecular analysis of the nac gene family in rice. Mol. Gen. Genet. 2000, 262, 1047–1051. [Google Scholar] [CrossRef]
- Guérin, C.; Roche, J.; Allard, V.; Ravel, C.; Mouzeyar, S.; Bouzidi, M.F. Genome-wide analysis, expansion and expression of the NAC family under drought and heat stresses in bread wheat (T. aestivum L.). PLoS ONE 2019, 14, e213390. [Google Scholar] [CrossRef] [PubMed]
- Liu, M.; Ma, Z.; Sun, W.; Huang, L.; Wu, Q.; Tang, Z.; Bu, T.; Li, C.; Chen, H. Genome-wide analysis of the NAC transcription factor family in Tartary buckwheat (Fagopyrum tataricum). BMC Genom. 2019, 20, 113. [Google Scholar] [CrossRef] [PubMed]
- Mohanta, T.K.; Yadav, D.; Khan, A.; Hashem, A.; Tabassum, B.; Khan, A.L.; Abd Allah, E.F.; Al-Harrasi, A. Genomics, molecular and evolutionary perspective of NAC transcription factors. PLoS ONE 2020, 15, e0231425. [Google Scholar] [CrossRef] [PubMed]
- Ooka, H.; Satoh, K.; Doi, K.; Nagata, T.; Otomo, Y.; Murakami, K.; Matsubara, K.; Osato, N.; Kawai, J.; Carninci, P. Comprehensive analysis of NAC family genes in Oryza sativa and Arabidopsis thaliana. DNA Res. 2003, 10, 239–247. [Google Scholar] [CrossRef]
- Le, D.T.; Nishiyama, R.; Watanabe, Y.; Mochida, K.; Yamaguchi-Shinozaki, K.; Shinozaki, K.; Tran, L.S.P. Genome-wide survey and expression analysis of the plant-specific NAC transcription factor family in soybean during development and dehydration stress. DNA Res. 2011, 18, 263–276. [Google Scholar] [CrossRef]
- He, F.; Zhang, L.; Zhao, G.; Kang, J.; Long, R.; Li, M.; Yang, Q.; Chen, L. Genome-Wide Identification and Expression Analysis of the NAC Gene Family in Alfalfa Revealed Its Potential Roles in Response to Multiple Abiotic Stresses. Int. J. Mol. Sci. 2022, 23, 10015. [Google Scholar] [CrossRef]
- Nie, G.; Yang, Z.; He, J.; Liu, A.; Chen, J.; Wang, S.; Wang, X.; Feng, G.; Li, D.; Peng, Y.; et al. Genome-Wide Investigation of the NAC Transcription Factor Family in Miscanthus sinensis and Expression Analysis Under Various Abiotic Stress. Front. Plant Sci. 2021, 12, 766550. [Google Scholar] [CrossRef] [PubMed]
- Zou, Z.; Xie, G.; Yang, L. Papain-like cysteine protease encoding genes in rubber (Hevea brasiliensis): Comparative genomics, phylogenetic, and transcriptional profiling analysis. Planta 2017, 246, 999–1018. [Google Scholar] [CrossRef] [PubMed]
- Rui, Z.; Pan, W.; Zhao, Q.; Hu, H.; Li, X.; Xing, L.; Jia, H.; She, K.; Nie, X. Genome-wide identification, evolution and expression analysis of NAC gene family under salt stress in wild emmer wheat (Triticum dicoccoides. L). Int. J. Biol. Macromol. 2023, 230, 123376. [Google Scholar] [CrossRef] [PubMed]
- Magadum, S.; Banerjee, U.; Murugan, P.; Gangapur, D.; Ravikesavan, R. Gene duplication as a major force in evolution. J. Genet. 2013, 92, 155–161. [Google Scholar] [CrossRef] [PubMed]
- Kamal, N.; Tsardakas Renhuldt, N.; Bentzer, J.; Gundlach, H.; Haberer, G.; Juhász, A.; Lux, T.; Bose, U.; Tye-Din, J.A.; Lang, D.; et al. The mosaic oat genome gives insights into a uniquely healthy cereal crop. Nature 2022, 606, 113–119. [Google Scholar] [CrossRef] [PubMed]
- Brosius, J. Retroposons—Seeds of evolution. Science 1991, 251, 753. [Google Scholar] [CrossRef] [PubMed]
- Vives-Peris, V.; López-Climent, M.F.; Pérez-Clemente, R.M.; Gómez-Cadenas, A. Root Involvement in Plant Responses to Adverse Environmental Conditions. Agronomy 2020, 10, 942. [Google Scholar] [CrossRef]
- Babu, M.M.; Iyer, L.M.; Balaji, S.; Aravind, L. The natural history of the WRKY-GCM1 zinc fingers and the relationship between transcription factors and transposons. Nucleic Acids Res. 2006, 34, 6505–6520. [Google Scholar] [CrossRef] [PubMed]
- Wang, W.; Yuan, Y.; Yang, C.; Geng, S.; Sun, Q.; Long, L.; Cai, C.; Chu, Z.; Liu, X.; Wang, G.; et al. Characterization, Expression, and Functional Analysis of a Novel NAC Gene Associated with Resistance to Verticillium Wilt and Abiotic Stress in Cotton. G3 2016, 6, 3951–3961. [Google Scholar] [CrossRef]
- Yang, Z.; Nie, G.; Feng, G.; Han, J.; Huang, L.; Zhang, X. Genome-wide identification, characterization, and expression analysis of the NAC transcription factor family in orchardgrass (Dactylis glomerata L.). BMC Genom. 2021, 22, 178. [Google Scholar] [CrossRef]
- Tariq, R.; Hussain, A.; Tariq, A.; Khalid, M.H.B.; Khan, I.; Basim, H.; Ingvarsson, P.K. Genome-wide analyses of the mung bean NAC gene family reveals orthologs, co-expression networking and expression profiling under abiotic and biotic stresses. BMC Plant Biol. 2022, 22, 343. [Google Scholar] [CrossRef]
- Zhang, X.; Long, Y.; Huang, J.; Xia, J. OsNAC45 is Involved in ABA Response and Salt Tolerance in Rice. Rice 2020, 13, 79. [Google Scholar] [CrossRef] [PubMed]
- Mijiti, M.; Wang, Y.; Wang, L.; Habuding, X. Tamarix hispida NAC Transcription Factor ThNAC4 Confers Salt and Drought Stress Tolerance to Transgenic Tamarix and Arabidopsis. Plants 2022, 11, 2647. [Google Scholar] [CrossRef] [PubMed]
- Mao, X.; Zhang, H.; Qian, X.; Li, A.; Zhao, G.; Jing, R. TaNAC2, a NAC-type wheat transcription factor conferring enhanced multiple abiotic stress tolerances in Arabidopsis. J. Exp. Bot. 2012, 63, 2933–2946. [Google Scholar] [CrossRef] [PubMed]
- Bai, Y.; Han, N.; Wu, J.; Yang, Y.; Wang, J.; Zhu, M.; Bian, H. A transient gene expression system using barley protoplasts to evaluate microRNAs for post-transcriptional regulation of their target genes. Plant Cell Tissue Organ Cult. 2014, 119, 211–219. [Google Scholar] [CrossRef]
- Eddy, S.R. Accelerated profile HMM searches. PLoS Comput. Biol. 2011, 7, e1002195. [Google Scholar] [CrossRef]
- Séverine, D.; Gabella, C.; Frédérique, L.; Stockinger, H.; Durinx, C. Expasy, the Swiss Bioinformatics Resource Portal, as designed by its users. Nucleic Acids Res. 2021, 49, 216–227. [Google Scholar]
- Voorrips, R.E. MapChart: Software for the Graphical Presentation of Linkage Maps and QTLs. J. Hered. 2002, 93, 77–78. [Google Scholar] [CrossRef] [PubMed]
- Wang, Y.; Tang, H.; Debarry, J.D.; Tan, X.; Li, J.; Wang, X.; Lee, T.H.; Jin, H.; Marler, B.; Guo, H.; et al. MCScanX: A toolkit for detection and evolutionary analysis of gene synteny and collinearity. Nucleic Acids Res. 2012, 40, e49. [Google Scholar] [CrossRef]
- Chen, C.; Chen, H.; Zhang, Y.; Thomas, H.R.; Frank, M.H.; He, Y.; Xia, R. TBtools: An integrative toolkit developed for interactive analyses of big biological data. Mol. Plant 2020, 13, 1194–1202. [Google Scholar] [CrossRef]
- Larkin, M.A.; Blackshields, G.; Brown, N.P.; Chenna, R.; McGettigan, P.A.; McWilliam, H.; Valentin, F.; Wallace, I.M.; Wilm, A.; Lopez, R.; et al. Clustal W and clustal X version 2.0. Bioinformatics 2007, 23, 2947–2948. [Google Scholar] [CrossRef] [PubMed]
- Kumar, S.; Stecher, G.; Li, M.; Knyaz, C.; Tamura, K. MEGA X: Molecular Evolutionary Genetics Analysis across computing platforms. Mol. Biol. Evol. 2018, 35, 1547–1549. [Google Scholar] [CrossRef] [PubMed]
- Lescot, M. PlantCARE, a database of plant cis-acting regulatory elements and a portal to tools for in silico analysis of promoter sequences. Nucleic Acids Res. 2002, 30, 325–327. [Google Scholar] [CrossRef] [PubMed]
- Duan, Z.L.; Han, W.H.; Yan, L.; Wu, B. Reference gene selections for real time quantitative PCR analysis of gene expression in different oat tissues and under salt stress. Biol. Plant. 2020, 64, 838–844. [Google Scholar] [CrossRef]
- Livak, K.J.; Schmittgen, T.D. Analysis of Relative Gene Expression Data using Real-Time Quantitative PCR and the 2−ΔΔCT Method. Methods 2002, 25, 402–408. [Google Scholar] [CrossRef] [PubMed]
- Wu, B.; Munkhtuya, Y.; Li, J.; Hu, Y.; Zhang, Q.; Zhang, Z. Comparative Transcriptional Profiling and Physiological Responses of Two Contrasting Oat Genotypes under Salt Stress. Sci. Rep. 2018, 8, 16248. [Google Scholar] [CrossRef] [PubMed]
- Chen, Y.; Qiu, K.; Kuai, B.; Ding, Y. Identification of an NAP-like transcription factor BeNAC1 regulating leaf senescence in bamboo (Bambusa emeiensis ‘Viridiflavus’). Physiol. Plant. 2011, 142, 361–371. [Google Scholar] [CrossRef] [PubMed]
- Yang, Y.; Li, R.; Qi, M. In vivo analysis of plant promoters and transcription factors by agroinfiltration of tobacco leaves. Plant J. 2000, 22, 543–551. [Google Scholar] [CrossRef] [PubMed]
- Wu, H.; Wu, X.; Li, Z.; Duan, L.; Zhang, M. Physiological Evaluation of Drought Stress Tolerance and Recovery in Cauliflower (Brassica oleracea L.) Seedlings Treated with Methyl Jasmonate and Coronatine. J. Plant Growth Regul. 2012, 31, 113–123. [Google Scholar] [CrossRef]
- Tan, W.; Liu, J.; Dai, T.; Jing, Q.; Cao, W.; Jiang, D. Alterations in photosynthesis and antioxidant enzyme activity in winter wheat subjected to post-anthesis water-logging. Photosynthetica 2008, 46, 21–27. [Google Scholar] [CrossRef]
- Zhang, P.; Fu, J.; Hu, L. Effects of alkali stress on growth, free amino acids and carbohydrates metabolism in Kentucky bluegrass (Poa pratensis). Ecotoxicology 2012, 21, 1911–1918. [Google Scholar] [CrossRef]
- Issac, R.A.; Kerber, J.D. Atomic Absorption and Flame Photometry: Techniques and Uses in Soil, Plant, and Water Analysis. In Instrumental Methods for Analysis of Soils and Plant Tissue; Soil Science Society of America: Wiscousin, MI, USA, 1977; pp. 17–37. [Google Scholar]
- Munns, R.; Wallace, P.A.; Teakle, N.L.; Colmer, T.D. Measuring Soluble Ion Concentrations (Na+, K+, Cl−) in Salt-Treated Plants. Methods Mol. Biol. 2010, 639, 371–382. [Google Scholar] [PubMed]
Disclaimer/Publisher’s Note: The statements, opinions and data contained in all publications are solely those of the individual author(s) and contributor(s) and not of MDPI and/or the editor(s). MDPI and/or the editor(s) disclaim responsibility for any injury to people or property resulting from any ideas, methods, instructions or products referred to in the content. |
© 2024 by the authors. Licensee MDPI, Basel, Switzerland. This article is an open access article distributed under the terms and conditions of the Creative Commons Attribution (CC BY) license (https://creativecommons.org/licenses/by/4.0/).






